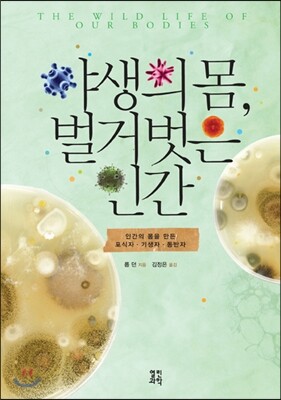

2023년 읽은 책

에토스
- 작성일
- 2023.1.8
경제학, 철학, 진화심리학, 환경문제 등 갖가지 분야에 해박한 지식을 가지고 다방면에서 명쾌한 해석을 내려줍니다. 의학은 사회과학이며 정치는 대규모 의료에 불과-루돌프 피르호(30쪽) 사회적 평가 위협(30쪽) 자기고양적 편견, 기만적 우월감, 워비곤 호수 효과(117쪽) 인류가 약 25만 년 전 맹수 사냥을 개발했을 무렵 평등주의가 확산되기 시작했다는 설이 가장 설득력 있는 설명이다.(210쪽) 타인(자신은 예외)의 행동을 환경이 아니라 타고난 개인의 특성에서 기인한 것으로 설명하려는 인간의 경향을 가리켜 기본적 귀인 오류라고 한다.(332쪽) 2023.12.29.금
인간의 아기는 4.5%의 지방, 1.1%미만의 단백질, 6.8%의 락토오스,, 87%의 물로 구성된 우유를 좋아하고 또 필요로 한다.(22쪽) 곳곳에 숨겨둔 호락호락 하지 않은 표현들 언제나 자신의 일탈을 기준으로 삼는 유럽인들의 습관(17쪽) 로마의 제국주의를 모델로 삼았던 영국인들(59쪽) 콜럼버스의 인류 역사상 가장 심각한 범죄 중 하나인 흑인 노예무역(101쪽) 여성을 판단하려는 충동(117쪽) 메이플라워호는 종교적 극단주의자들(139쪽) 여성의 신체 관리에 관해 목에 가장 핏대를 올리는 사람들(209쪽) 모든 곳의 남성들은 여성들의 의무에 무게를 둔(210쪽) 구정물 우유와 영아 사망률 그리고 6개월 수명의 젖소(214~225쪽) 네슬레의 상술(407~413쪽)과 핵실험(430쪽) 여러 부문에서 지식의 깊이를 알 수 없을 정도로 박식하다. 2023.12.17.일
일본인의 책을 읽을 때마다 뭐랄까 말할 수 없는 가벼움을 느끼며 약간의 실망을 하려는 순간, 지은이는 이렇게 말한다. 타인에게 모든 것을 맡기면 자신의 사고가 멈춘다.(260쪽) 남에게 휘둘리지 않고 자신이 주체가 되어 진실을 찾을 수 있는 혜안과 지혜가 필요하다. 예수가 마태 복음에서는 고귀한 집안의 출신으로, 누가 복음에서는 서민 계급이 되고, 마가 복음에서는 가난한 목수의 아들로 기록되어 있다.(71쪽) 로마의 토지세와 인두세의 과중으로 이슬람으로 개종하면 인두세 면제가 효력을 발휘했다(197~204쪽)는 설명은 로마의 몰락에 대해 훨씬 피부에 와닿는 견해다. 시아파-알리를 따르는 사람들, 이란+이라크 수니파-이슬람의 관행을 따르는 사람들, 사우디 아라비아 등 다수파(217~223쪽) 2023.12.09.토.
대니얼 마코비츠의 <엘리트 세습>의 초기버전이며 알기쉽게 설명하면서도 날카로운 비판은 절대 가볍지 않다. 부유한 사람들에게는 꿈과 현실의 차이가 더 좁다.(81쪽) 철학자 애덤 스위프트는 "어떤 부모를 갖게 될지는 전적으로 운이지만 어떤 자녀를 갖게 될지는 그렇지 않다."(65쪽) 미식축구 코치 배리 스위처는 그들은 "삼루에서 태어났으면서도 자기가 삼루타를 친 줄 안다."(29쪽) 대학에 다니는 것의 장점인 더 높은 소득을 위한 잠재력은 획득하지 못한 채, 대학에 다니는 것의 단점인 빚만 갖게 되는 것이다.(199쪽) 선출직 정치인은 아무리 본인이 원한다 해도 유권자들보다 더 앞서 나갈 수는 없다.(207쪽) 정치인에게 책임을 전가하고 자신은 무책임한 평론가로 남아 고고한 척하지 말자. 2023.12.05.화
책을 읽는 내내 숨이 콱콱 막히는 느낌이다. 답답한 현실과 이겨낼 수 없는 거대한 세력에 대한 두려움, 그리고 아무것도 모르는 사람들 하지만 모두를 멸망의 구렁텅이를 향한 끝없는 경주 한가운데 서있는 것같다. 국제 석유 자본과 핵무기 산업은 미국 및 유럽에서 같은 자본으로 경영되는 동족회사다.(306쪽) 모건상사와 록펠러의 결합, 거기에 숟가락을 얹는 로스차일드 자본은 잡아먹을듯이 경쟁하지만 이익을 위해서는 엄청 끈끈하게 잘 뭉치는데 우리의 방어는 사소한 차이에 집착해 왜 이리 허술할까? 원자력의 평화적 이용은 끝없는 이익을 담보해줄 빛나는 미래(252쪽) 일시적인 전쟁의 이익을 평상시로 항구화하려는 잔머리 731부대를 뭐라하기 힘든 미국내 인체실험(203~213쪽)은 저들을 인류라 부르기 민망할 정도다. 2023.11.28.화
사람들이 그것을 아메리칸 드림이라고 부르는 이유는 그것을 믿으려면 잠이 들어야 하기 때문이다.-조지 칼린(11쪽) 이 경주는 세대가 바뀔 때마다 판을 다시 짜서 새로운 출발점에서 새롭게 시작하는 것이 아니다. 그것은 오히려 부모로부터 출발점을 물려받는 릴레이 경주에 가깝다. 부모에게서 자녀에게로 배턴이 전달된 후에도 부모와 자녀는 한동안 함께 달린다.(17쪽) 소득의 불평등보다 부의 격차가 훨씬 심각한 문제다. 소득 상위 10%: 전체 소득 중 36%, 하위 20%: 5.1% 부 상위 10%: 총가계 순자산의 74.5%, 하위 50%: 1.1%(128~9쪽) 국가가 개인의 부의 축적을 가능케 하고, 보호하고, 장려하기 때문에 국가는 개인의 재산에 대한 권리를 공동 상속한다.(310쪽) 혼합 경제란, 경제의 일부는 시장의 힘에 의해 돌아가고, 나머지 부분은 정부의 결정에 의해 운영되는 것을 뜻한다.(312쪽) 2023.11.21.화.
시장은 인간과 하늘에 진실하지 않을뿐더러 앞을 내다보는 지혜도 없다.(278쪽) 이 단 한 문장으로 자본주의의 최후의 보루인 시장을 사정없이 힐난한다. 우리는 대지의 후원을 받아서 수십억 명의 인구를 먹여 살릴 수 있었다. 그렇지만 대금을 상환한 일은 없다. 농업은 자연에 폭력을 행사하는데, 우리가 항상 손에 충분한 반창고를 들고 있을 것인가?(29쪽) 식품제국의 실수 3가지 가정: 비옥한 지구, 안정적인 기후, 소품종 대량 생산(28~31쪽) 기원전 133년 티베리우스 그라쿠스의 토지 개혁: 새로운 속주->식량 수탈->곡물 가격 폭락->이탈리아 본토 소농 몰락->지배층 토지 인수->플랜테이션화->노예 노동력 이용->포도 등 특화작물 재배->도시인구 증가->식량 부족(99~101쪽) 빵 관리법: 곡물의 밭떼기 거래를 금하고 반드시 정해진 날애 시장에서만 팔도록 강제했다. 이 시대에 자본은 경계의 대상이었다.(306~7쪽) 2023.11.15.수.
스마트한 지배는 지속적으로 우리의 의견, 필요, 선호를 소통하라고, 삶을 서술하라고, 게시하라고, 공유하라고, 링크로 걸라고 요구한다. 이때 자유는 억압되기는커녕 철저히 혹사된다. 자유가 결국 통제와 제어로 전복되는 것이다.(24쪽) 어떤 사람에 대한 데이터가 많이 모일수록 그 사람에 대한 감시와 제어는 더 잘 이루어지고 경제적으로도 더 잘 착취된다. 놀이터로서의 스마트폰은 디지털 파놉티콘임이 드러났다.(50쪽) Quantified Self(정량화된 자기 자신)의 모토는 '숫자를 통한 자기 이해'이다.(51쪽) Binge Viewing(Watching) 생각 없는 시청이 시리즈 소비를 특징짓는다.(97쪽) 상관관계는 지식의 가장 원시적인 형식, 종결 형식을 띤 이론은 사물을 개념적 틀에 담은 후 그것을 이해 가능한 것으로 만든다.(102~3쪽) 스토리텔링은 자기 자체로는 가치 없는 사물을 가치 있는 재화로 변화시킨다.(135쪽) 2023.11.05.일.
루소의 저작을 읽어보지는 못했고 이 참회록만 가지고 판단하기는 그렇지만 자신의 운명에 대한 과도한 피해의식과 불행에 모든 책임 전가 및 소심한 성격이 어우러진 외곬수라는 생각이 든다. 사실 자신의 자녀를 고아원에 보낸 까닭이 궁금해서 읽게 되었는데, 내 어린 것들의 앞길과 그 어머니와 나의 관계를 자연과 정의와 이성의 법칙, 또 종교의 법칙에서 비추어 검토했다(386쪽)고 한다. 내가 보기에 진실은 자신도 고백했다시피 자신을 닮을까봐 (방랑자의 협잡꾼), 애들을 버릴 운명에 이를까봐, 애들이 부모를 싫어할까봐, 애들이 커서 부모를 거역할까봐 핑계를 대면서 자신도 아이처럼 양육(고아원에서 자라기)되기를 바란다(387~8쪽)고 앞뒤가 다르게 말한다. 앞으로 일어날 사건(애들을 버릴 것같아서 등등)을 덮기 위해 그랬다는 점, 숨길 것도 없다면서 테레즈를 배려(숨기려 함)했다고 한 점, 자신의 잘못이라고 시인하면서 이를 비난하는 친구를 적으로 생각하는 점에서 무수한 헛점과 모순투성이를 본다. 하지만 446쪽에 이르러 테레즈 이외의 처가식구들, 특히 장모에 대한 분노로 자녀를 맡길 수 없었다고 고백한다. 조금은 이해한다. 테레즈의 인품을 높이 평가(446쪽)한다면서도 성욕의 대상(445쪽)일 뿐이며 아줌마, 가정부로 지칭하는 등 엄청 무시한다. 회한은 행운에 잠겨 있을 때는 얌전하게 잠자고 불행해지면 보채기 시작한다.(106쪽) 2023.11.02.
조지 W. 부시가 백악관에 들어가고 나서 세 번의 주가 대폭락-2001년 9.11, 2002년 분식회계 등 기업비리 스캔들, 2008년 리먼브라더스 쇼크로 발생한 금융위기 2002년 10월 최저치를 찍은 주가지수 7,286.27포인트는 6년 후에도 무너지지 않음(31~32쪽) 검은 목요일(1929년 10월 24일)이 파시즘과 제2차세계대전을 불러일으키고, 초대형 재벌의 독점지배를 전 세계로 확산시키는가 하면 마침내 원자폭탄과 수소폭탄이라는 악마의 무기를 만들었다.(39쪽) CME그룹은 4대 선물거래소(환율, 곡물, 원유, 금)를 합병(53쪽) 모든 악의 근원은 투기자본(54쪽) 부시정권의 2002~2006년 사이 최상위 1%의 실질 소득은 연평균 11% 상승, 나머지 99%는 연평균 0.9%임. 0.9%는 늘고 있으나 전체 부에서 차지하는 비율은 더 크게 감소하여 차이가 더 늘어나는 것이 빈부격차의 원리(102쪽) 그저 한숨만 푹푹 2023.10.12.목
잔잔하고 편안하게 글을 쓰지만 내용은 몹시 가슴아픈 이야기들 뿐이다. 하지만 첨예한 부분에서 제대로된 입장이 안 보인다. 특히 유전자변형양식에 관한 부분(285쪽) 원주민들은 자연이 주는 풍성한 선물은 결코 당연한 것이라 여기지 않았다.(168쪽) 영국 정착민은 아메리카 원주민을 거의 이해하지 못했고, 원주민들이 너무 어리석거나 시대에 뒤떨어져서 자기 소유물들을 충분히 활용하지 못한다고 생각했다. 그러나 영국인은 정기적으로 기근을 겪는데도 원주민은 굶주리지 않았다.(131~2쪽) 무지는 지식보다 빈번하게 확신을 낳는다.-다윈 부화장은 인간이 자연을 능가할 수 있다는 믿음에 뿌리내린 산업혁명의 산물. 물고기 양식은 천연물을 취해서, 통제가 가능하고 먹을 수 있는 인조품으로 재설계할 수 있다는 믿음에서 비롯 (260쪽) 우리에게 운이 다했다는 공감대가 과학자들 사이에서 커지고 있다.(419쪽) 2023.10.09.월
지은이는 서문에서 모든 것을 잃은 것처럼 보여도 희망의 불씨는 남아 있다(19쪽)고 했지만 희망이라는 것이 진짜 있는 것인지 미래는 암울하기만 하다. 국가 간 배출량의 차이로 미국인 1인당 50제곱미터, 중국인은 22제곱미터의 빙하를 녹인다(41쪽)고 하나 중국수입품을 쓰는 모든 나라는 더 책임을 느껴야 한다. 멸종의 에스컬레이트를 탔다(84~91쪽)는 주장에 전적으로 동의하나 롭 던이 미래의 자연사에서 밝혔듯이 인류 등 대형종에 국한된 이야기이고 결국 원래처럼 박테리아와 바이러스의 세상으로 돌아간다. 우리가 지구의 영원한 주연일 수 없다. 역할을 제대로 못하기 때문에 보다 더워진 세상에서는 서늘한 지역이 극지방쪽으로 줄어들고 산지에서는 꼭대기 쪽으로 줄어든다.(259쪽) 이 말보다 더 무서운 말이 있을까? 여기에는 식량 생산 감소, 물 부족, 해수면 상승, 인구 증가는 고려하지도 않았다. 2°상승했을 경우 북반구의 도시들은 남쪽으로 1,000킬로미터 떨어진 더 따뜻한 지역의 현재 기후와 비슷하다. 1년에 20킬로미터, 하루에 약 54미터, 또는 시간당 2.25미터의 속도로 남하한다.(135쪽) 우리는 응당 그런 벌을 받아야 한다.(151쪽) 2023.09.30.토
서문만 읽고 지은이의 내공과 통찰력, 표현력에 무한한 존경을 보냅니다. 깨달음은 해방을 불러온다.(32쪽) 능력주의는 소득과 부의 최대 원천이 토지가 아닌 노동력인 세상을 위해 맞춤제작된 귀족 제도(33쪽) 희망은 계획이 아니다.(36쪽) 적법한 절차와 법치주의는 소득과 부에 대한 능력주의의 정당화에 근거해 재산의 규모를 고려하지 않고 일률적으로 적용하는 것으로 엘리트가 소득과 재산 보호에 마음껏 이용해왔다. 일반적으로 적용 가능한 세금과 규제를 통해 재분배하려는 민주적인 조치를 좌절시키는 것(145쪽) 2차 세계대전 후 미국은 대압축시대라 부를 정도로 엘리트계층과 중산층이 같은 삶을 살았을 뿐만 아니라 같은 물건을 소유했다.(116~7쪽) 그러나 아이비리그, 실리콘밸리, 월가로 상징되는 능력주의는 폼나는 직장을 통해 부와 소득을 독점한다. 중산층은 어쩔 수 없이 암울한 직장으로 밀려나 기대수명마저 6~9년이 적다.(394쪽) 깨달음이 깊은 분노와 절망적인 좌절을 일으키 않기를 바랄 뿐이다. 2023.09.22.금
행동하거나 행동하지 않은 결과(154쪽)는 마찬가지이다. 아시아에서 아메리카로의 탈출은 1492년 콜럼버스의 침략으로 수천 만 명의 아메리카 원주민의 "대살상"으로 끝났다. 자신들이 일으킨 끔찍한 결과를 마주볼 수가 없어서 아메리카 대륙에 인류가 번성한 적이 없었다고 거짓말을 지껄인다. 그래서 잉카와 마야문명을 발견한 후, 고도의 문명을 부인하고 자신들의 죄를 덮기 위해 사라져버린 신비한 부족의 흔적처럼 얼버무린 것같다. 이 때 유럽으로 이주한 감자는 아일랜드에서 감자마름병이라는 무서운 천적에게 덜미를 잡힌다. 1845년에 발생한 대기근의 여파로 800만 명의 아일랜드 인구는 100만명 아사, 100만명 이주로 25%를 사라지게 한다.(106~113쪽) 메가플레이트 실험에서 세대기간 20분인 대장균이 대략 88시간(264세대, 5~8천년)이 지나자 가장 낮은 농도의 항생제에서 살아남기 시작하고 10~12일(720~864세대, 14,000~26,000년)만에 3,000배의 치명적인 항생제에도 내성을 갖추게 된다.(254~269쪽) 2023.09.08.토
BC384~322 2,300년 전 사람의 말인데 왜 이리 현재를 보는 것 같은지 제대로된 법률의 가장 큰 특징은 가능한 한 많은 것을 미리 정해 놓고, 재판관들이 재량으로 결정할 수 있는 부분을 가능한 한 줄이는 것이다. 법률 제정이 오랜 시간에 걸친 숙고 후에 이루이는 반면, 판결은 단기간에 이루어지기 때문(12~3쪽) 들었지? 판새, 검새들아 말로 신뢰를 주는 방법:화자의 성품(가장 강력), 청중의 심리 상태, 증명하는 말 자체(17쪽) 합법적인 것은 대체로 이롭지만, 합법적으로 사형을 당하는 것은 바람직하게 여겨지지 않기 때문이다.(187쪽) 사형제에 대한 회의론 사람이 태어난 첫날에는 추억할 것은 아무것도 없고 모든 게 전부 희망할 것뿐이다. 젊은이는 교육 받은 것과 다르게 생각하는 법을 알지 못한다.(152쪽) 노인은 욕구에서 놓여나서 이득의 노예(155쪽) 노인이 연민을 느끼는 이유는 모든 일을 자기도 얼마든지 겪을 수 있다고 생각해서(156쪽) 감정들에 관한 정의는 심리학 책을 보는듯 삶에 대한 통찰에서 지혜로운 철학자의 모습을 정치제도에 관한 부분은 날카로운 비평가를 보는듯 2023.08.27.일
2023.08.12.토.김세진빌림 1933년 4월 5일 플랭크린 D. 루스벨트 민간의 금 보유 금지. 금의 가격이 올라가면 디플레이션 화폐의 속성 때문에 유동성이 심각하게 훼손되어 소비와 투자가 얼어붙을 염려.(221쪽) 1971년 8월 15일 닉슨 미국 달러를 금에 고정시키지 않겠다. 브레튼우즈 체제 파기. 브레튼우즈:달러를 국제 결제수단을 삼는다는 것과 달러를 금에 고정시킨다는 내용(153쪽) 금본위제로의 회귀라는 기대감에서 비트코인을 환영하는 사람들이 적지 않다. 그런데 비트코인은 실질적으로 아무것도 보증하지 못한다는 생각에 부딪혀 고전하고 있다. 실물화폐라는 개념이 비트코인의 확산을 저지하는 장애물인데 반해 실물화폐의 대표 격인 금본위제가 비트코인에 대한 철학적 지지층이다.(158쪽) 금본위제의 파기가 결국 원인인데 소비와 투자라는 달콤한 마약에 중독된 우리가 끊을 수 있을까라는 자본의 은근한 협박을 이겨낼 수 있으려나 2023.08.17.목
모든 것을 이분법적으로 나누어 생각하는 습관 단순하고 명쾌한 판단을 추구하는 습성 어둠은 밤과 죽음의 편이고, 빛은 낮과 생명을 의미한다. 어둠에 대한 인류의 원초적 불안감은 눈이 밤에 잘 기능하지 못하고, 명암을 구분하는 능력을 잃어버리고 색깔을 구분하는 데 익숙해졌기 때문이다.(98~100쪽) 인종주의는 언어를 토대로 선전선동이 만들어낸 현상일 뿐(96쪽) 진화가 인류의 몸 '속'에서는 매우 빨리 진행되지만 인류와 '함께' 진행될 때는 매우 느리게 진행된다.(116쪽) 종의 다양성은 풍요가 아니라 결핍을 말해준다.(148쪽) 지금까지 어떤 고등생물의 종도 소멸을 피하지 못했다. 지속적으로 존재하는 것은 지극히 작고 가장 단순한 형태의 생명체라 할 수 있는 미생물밖에 없다. 모든 고등생물은 우수한 조직의 장점을 누리는 대신 필멸이라는 운명을 피하지 못한다. 소멸은 아주 복잡하고 바용이 많이 드는 존재로서의 특징이다.(219쪽) 2023.08.07.월
자본주의의 탐욕은 다음 두 마디로 정리할 수 있을듯 하다. 이윤은 사유화, 비용은 사회화(157쪽) 로더데일 백작 제임스 메이틀랜드, 로더데일의 역설:사적 부가 증가하면 공적 부가 줄어든다. 신고전파는 사적 소득과 부만 계산하므로 절대 파악할 수 없는 것.(82~4쪽) 공급 독점->공급 제한->희소성->가격 상승->이윤 극대화->가외로 보조금: 장기적인 부족을 만들어낸 댓가로 단기 이윤 취득(143~150쪽) Natural Capital Committee(164쪽)자연은 자본이 아니다.(173쪽) 대처의 후예다운 천박함. 5대 빅테크기업(애플, 마이크로소프트, 알파벳-유튜브, 페이스북, 아마존)은 두번째 도금시대의 베헤모스(성서에 등장하는 거대 괴물)로 519개 유사 기업을 사드려 자유시장과 경쟁을 묵살한다.(326쪽) 그리고는 작가 데이비드 포스터 월리스가 "총체적 소음"이라고 부른 것을 만들어 주의력결핍장애를 낳는다.(329쪽) 2023.07.30.일
군락을 이루재 않는 한 곤충이 불임이라면 진화가 저지른 실수겠지만, 군락에 속하는 곤충이 불임이라면 이야말로 진화가 이룬 기적이다.(46~8쪽) 개미굴 입구를 막는 거북이개미속종, 감염된 호리가슴개미의 죽음, 꿀벌의 체온유지는 놀랍다. 엄마한테서 양분을 얼마나 쥐어짤지를 놓고 모계와 부계 유전자가 다툰다(97쪽)는 사실과 부계 유전자의 발현으로 임신 합병증, 임신 당뇨병을 일으키고(99쪽) 태어나서도 그 증거로 보이는 프라더-윌리증후군과 안젤만 증후군은 끔찍하다.(103쪽) 게다가 침투성 태반(101쪽)의 부작용, 암과 자궁외임신은 두렵다. 줄무늬몽구스 암컷을 피임시, 열위 서열 암컷일 때는 새끼들이 살아남지만 지배층 암컷일 경우 영아살해가 일아난다.(164쪽) 단수이배체(개미, 꿀벌, 말벌:수컷은 단수체, 암컷은 이배체)와 이배체 (인간)의 차이에 따른 자매들의 반란은 쇼킹하다.(164~170쪽) 크리스토퍼 보엠의 역전된 지배 위계(300쪽) 높은 지위를 얻을 길은 힘이 아니라 설득이다.(304쪽) 역시 아리스토텔레스가 진리다. 2023.07.16.일
제목에 비해 내용은 조금 까다롭고 많은 주 때문에 읽기가 수월하지 않지만, 그냥 지나쳐버리고 대수롭지 않게 생각했던 부분을 파헤친다. 쥐가 고양이에게 잡아먹히면, 쥐의 몸을 이루던 원자는 고양이의 몸을 이루는 원자로 재편되어 존재를 이어간다.(24쪽) 루크레티우스에 따르면, 서로에게서 생명을 빌려온다.(26쪽) 척추동물은 나이가 들어도 혀는 항상 재생된다. 미각 수용 세포는 9~15일마다 교체(30쪽) 향미 사냥꾼 가설(64쪽)은 최적 섭식 이론(128쪽)을 무력화시킨다. 천천히 수축하는 근육- 지근-적색육-등(갈비), 어깨, 목, 발-향미가 풍부(146쪽) 어미그루는 자기 때문에 자식이 죽는 일을 막으려고 씨앗에 열매를 장착시킨다.(156쪽) 식물이 보상을 제공하려면 자신의 탄수화물과 지방, 단백질을 내어주어야 한다. 자손을 위해서 자기 자신을 내놓아야 하는 것(157쪽) 구토와 관련된 향-가르시아효과(186쪽) 고추는 조류를 산포자로 잡기 위해 캡사이신 생성(197쪽) 사람은 고추를 위험이 선사하은 생화학적 쾌락을 즐기기 위해(198쪽) 2023.07.06.목
생물(미생물 포함)과 공생하지 않는 인류의 어리석음의 결과에 대한 증거들을 나열하면서 답답한 마음을 토로하면서도 유머감각을 잃지 않는다. 맥락은 다를 수 있지만 대문 앞에 나와 있는 전형적인 노인들처럼 "너희들은 아무 것도 몰라"(333쪽)를 외쳐댄 인간의 가장 큰 장벽으로 우리의 뇌와 그에 따른 편견을 든다.(357쪽) 손힐이 생각하기에, 이성은 우리가 본능에 휩싸이는 것을 방지하지만, 이성은 깊이를 알 수 없고 거센 풍랑이 이는 바다 속에 발을 딛고 있는 것처럼 불완전하다.(306쪽) 그 예로 제이슨 포크너는 외국인 혐오증이 전염병 전파를 막기 위해 진화되었다고 주장한다.(311쪽) 조금 과장된 면도 있고 면죄부를 줄 수도 있기에 약간 불편했지만 오랜 습관은 사라지지 않고, 과거의 망령처럼 우리 곁에 머물고 있다.(318쪽)고 한탄한다. 충수(141~159쪽), 린 이스벨의 뱀과 시각의 연결(231~253쪽)은 흥미로웠다. 2023.06.25.일
1970년대 출간된 책임에도 자연선택은 평화로운 공존을 선택한 점, 동등한 능력을 보여주었다는 인종에 대한 생각(279쪽), 종 분화 없이 빈부격차(287쪽)와 계급제도(290쪽)에 대한 관점, 종교(294쪽)와 영국(296쪽)에 대한 날선 비판은 정말 뛰어나다. 자연선택에 의해 생태적 지위가 정해지면 종의 수도 정해진다. 그러나 제한적인 기회라는 특권을 어느 유전자가 누릴지 경쟁한다. 오로지 유전적으로 잊히지 않기 위해서(27~36쪽) 우리는 그리 탐욕적이 되었을까? 동물종의 개체 수는 생활양식을 영위할 기회에 의해서 결정되는 것이지, 종의 번식 방법에 의해서 결정되는 것은 아니다.(45쪽) 인구 대책이 애만 낳으라고 해봤자 아무 소용이 없는 이유이다. 키울 수 있는 환경과 잘 살아갈 수는 희망을 주지 않으면 백약이 무효이다. 특히 신자유주의 광풍이 몰아치는 한국에서는 더더군다나... 식물은 태양 에너지의 2%, 초식동물은 그것의 10%, 육식동물은 초식동물의 10% 이산화탄소가 식물의 생산 정도를 규정(71쪽) 적합한 동물이란 싸움을 잘하는 동물이 아니라 싸움을 한사코 피하는 동물이다.(194쪽) 메인주 포수들(233쪽)은 법칙을 지키는 새들에 대해 생각할 바를 많이 준다. 동물의 세력권과 인간의 재산권 비교(242쪽)는 창피하기만 하다.
만성 염증성 질환(크론병, 천식 , 알레르기, 다발경화증)은 부유한 국가에서 증가 위생가설(데이비드 스트랜천), 면역글로불린 항체, 아미시파와 후터파, 쥐들의 천식 반응은 우리가 도심을 떠났을 때 비염 또는 아토피 증상의 개선을 설명해준다. 일카 한스키(생태학), 타리 하텔라(전염병학), 레나 본 헤르첸(미생물학)(71~92쪽) 결핵(tuberculosis) 16~800년대 유럽 성인의 1/5 사망원인. 염소, 젖소, 쥐, 물개에 전파(97쪽) 경쟁해방(116쪽) 적과 너무 싸우지 마라. 그러면 전술을 모두 가르쳐주게 된다는 나폴레옹의 금언(195쪽)과 항생제가 밴 한천을 단 11일만에 뒤덮어버린 세균(273쪽)은 항생제와의 군비경쟁이 어떤 종말에 이르게 하는지 끔찍한 결과를 보여준다. 김치(281~7쪽)와 스타터(287~308쪽)는 우리가 나아가야할 생명 다양성의 방향을 알려준다. 2023.06.09.금
뭔가 음흉하고 음모론적이라는 선입견 때문에 주저했던 책인데 프란스 드 발의 언급으로 읽게 되었다. 그저 이탈리아의 분열에 따른 외세의 침략에 분개한 엄청나고 지속적인 불운으로 인해서 얼마나 부당한 학대를 당하고 있는(14쪽) 정치가의 저술 운명(fortuna)과 역량(virtu)(16쪽) 권력을 얻을 수 있을지언정 영광을 얻을 수 없다(65쪽)와 물질적 대가를 주고 얻은 우정은 소유될 수 없다(119쪽) 군주가 가질 수 있는 최선의 요새는 인민에게 미움을 받지 않는 것(150쪽)처럼 정치를 바라보는 공화주의자의 시각이 담겨 있다. "인간이 어떻게 살고 있는가"는 "인간이 어떻게 살아야 하는가"와은 너무나 다르다.(109쪽) 정치의 핵심은 상징과외양(126쪽, 247쪽) 지혜란, 다양한 위험을 평가하는 방법을 알고, 따라야 할 올바른 대안으로 가장 해악이 적은 대안을 선택하는 것(157쪽) 2023.06.01.목
민주주의 위기의 원인을 진단하고 이세고리아(자유롭게 말할 권리)와 파레시아를 참된 민주주의를 이끄는 원리라고 말한다. 파레시아(parrhesia, 참되게 말하기)자신이 생각하는 바, 참이라고 여기는 바, 정말로 참이라고 여기는 바를 말하는 것.(95쪽) 정보는 질주하며 진실을 지나치고, 진실은 정보를 따라잡지 못한다.(44쪽) 소비 및 소통 좀비(48쪽) 필터 버블은 나를 영구적인 "나-고리" 안에 빠뜨린다.(53쪽) 타인의 사라짐이, 경청 능력의 부재가 민주주의가 처한 위기의 원인(54쪽) 상호 가치 평가는 인간적 관계를 총체적 상업화에 예속시킴으로써 파괴한다.(92쪽) 2023.05.26.금
히로세 다카시의 제1권력, 엘렌 H 브라운의 달러에 버금가는 훌륭한 책. 신자유주의, 시카고학파에 대해 알려면 반드시 보아야 하는 책. 언론인이라고 하기에는 경제를 너무 잘 알고...우리는 너무 늦게 깨닫고... 그가 써놓은 글들은 분노와 슬픔의 칼이 되어 가슴속 깊이 밀려든다. 우리가 어렴풋이 알았던 사건들을 통해 칠레, 아르헨티나, 폴란드를 거쳐 한국까지 왜 우리는 이렇게 당해야 했는지 조목조목 살펴준다. 그들의 고통이 나의 고통이 되어 잠시 책을 덮어야 할 정도로 상처가 깊다. 2023.05.22.월
1971년 금본위제도의 폐지(23쪽)를 필두로 한 신자유주의의 탄생(밀턴 프리드먼의 통화주의과 공급중시 경제학)에 대한 역사는 소름끼치게 한다.(30~41쪽) 자본의 성장과 팽창의 다른 두 모습, 영국의 미국과 인도 식민지 통치(142~151쪽) 미국의 전략인 마셜플랜을 통한 일본과 독일>한국, 대만>중국으로 이어지는 경제구조 변화는 신자유주의가 승승장구했으나 중국의 부상으로 결국 일본의 침체와 아시아에 IMF를 불러오고 미중의 대결로 치닫는다.(152~161쪽) 보상적 소비주의(268~278쪽) 시장에 있는 것들을 공유의 장으로 불러온다면 많은 문제들이 해결될 것같다.(97~103쪽) 2023.04.16.일
사람들이 섭취하는 열량의 80%는 작물 12종, 90%는 15종(8쪽) 1800년대 영국은 차가 아니라 커피를 마셨다. 이 커피는 식민지 실론에서 수입했다. 커피녹병으로 커피가 전멸하여 농부들은 차를 심었다.(11~2쪽) 기호식품도 진정한 기호식품이 아니다. 그저 식민지가 싸게 공급하는 재료에 따라 바뀐다. 산꼭대기에 서식하는 종은 특별한 어려움을 맞을 것이다.이 종들에 필요한 추운 기후가 사라질 것이기 때문이다. 중간 지대에 서식하는 종들은 위로 올라갈 테지만, 예전 서식처보다 좁은 면적에 만족해야 한다.온난한 곳에서 자라는 작물은 북쪽으로 이동할 것이다. 열대지방의 기후는 더 뜨거워지고 건조해질지도 모른다.(84쪽) 기후변화에 따른 생태계의 변형에 대한 예측은 소름 끼치게 한다. 달려도 달려도 제자리에 머물러 있는 붉은 왕비 가설(217쪽)은 밥상 위에 다모클레스의 칼(223쪽)처럼 공진화의 위협을 보여준다. 2023.05.04.목
잡초의 가장 기본적인 특징은 연약한 식물이라는 것(29쪽), 경쟁사회에서 도망친 낙오자(31쪽)처럼 1만 년 전부터 인간이 만들어낸 특수한 환경에 적응(44쪽)해 왔다고 말한다. 골프장의 러프와 페어웨이, 그린에 적응한 새포아풀의 키에 관한 이야기(81쪽)는 기절할 것같은 놀라움을 준다. 진화는 유전적 변이와 환경에 적응한 자만이 살아남는 도태로 이루어진다.(83쪽) 인간은 정리하지 못하면 이해하지 못하는 생물이라서 여러가지로 분류해서 특징을 부여하려고 한다.(91쪽) 광합성=이산화탄소+물=포도당+산소+물(162쪽) 2023.03.27.월
닭의 수영장 구조에서 동료가 곤경에 처한 사실을 인지하고 어디로 가서 인간에게 도움을 구해야 하는지, 어떻게 해야 사람의 주의를 끄는지 알았다는 점이 놀랍다. (16쪽) 조류들 사이에서는 일부일처 관계가 일상적이지만 포유동물은 단 5%만이 암수가 한 쌍으로 결합을 한다.(143쪽) 일부일처제가 우리 인간 종에게 자연스러운 상태였던 적이 없다는 증거는 착실히 쌓여왔다. 실제로 과학자들은 사회적 일부일처제와 성적 일부일처제를 구별한다. 상대에게 성적으로 충실하지 않으나 계속해서 짝으로 지내는 동물들을 사회적 일부일처 동물이라고 본다.(178~180쪽) 의식적인 호흡을 해야하는 돌고래가 숨을 안 쉬고 자살하는 것과 동물원에 갇힌 침팬지의 자해 행위는 깊이 생각해볼 문제다.(238~245쪽) 유인원의 애도 사례를 보면 우리와 무엇이 다른지 찾아볼 수 없다.(253~264쪽) 2023.04.22.토
사람상과(사람, 침팬지, 긴팔원숭이, 보노보, 고릴라, 오랑우탄)는 꼬리가 없고, 몸집이 크고, 가슴이 편평한 영장류(134쪽) 사람과 침팬지, 꼬리감는원숭이, 마카크원숭이가 석기시대에 진입(145쪽) 유인원은 자신이 믿는 세상의 작용 방식을 바탕으로 논리적 연결을 추구한다.(91쪽) 상동 공통의 조상에서 유래한 공통의 특성, 상사(수렴진화) 각자 독자적으로 같은 방향으로 진화(박쥐와 고래의 반향정위, 곤충과 새의 날개, 영장류와 주머니쥐의 나머지 손가락과 마주 보는 엄지)(124~5쪽) 자신의 지지를 구하는 젊은 수컷에게 불규칙하게 지지를 보냄으로써 권력을 유지하는 칼룬데(273쪽) 일화기억, 장래 계획 세우기, 만족 지연 게다가 메타인지까지 동물의 생각의 증거는 차고 넘친다.(359쪽) 2023.04.10.월
산림파괴로 인한 서식지 환경 악화로 숙주들의 개체수 감소가 바이러스의 인간 공격이라는 악순환이 일어난다고 명쾌하게 밝혀준다.(52~70쪽) 알프 호른보리의 시공간 수탈과 데이비드 하비의 시공간 압축 이론(108~110쪽)은 새로운 시각을 제공해 준다. 제임스 오코너는 자본주의가 두 개의 아킬레스건, 과잉투자와 생산조건(인간과 자연)에 대한 수탈로 자멸한다고 말한다.(147~8쪽) 만족을 모르는 무제한의 인간 제국주의(226쪽)는 어찌 이 모든 죄를 감당하려는지 안타깝다. 2023.03.24.금
빛의 아름다운 윤곽이 그림자다.(75?) 언어의 기원은 지배자들의 권력선포이다. 언어는 가장 오래된 물건 점유과정의 잔향이다. 모든 낱말, 모든 이름이 니체에게는 하나의 명령이다.(83쪽) 마치 고독의 아픔이 녹아 신의 삶이 되는 것만 같다. 하나가 모두와 합쳐짐. 그것이 신의 삶이요, 그것이 안간의 하늘이다.(147?) 2023.01.31.화
만약 이 종이 짐승이라면, 나는 누구인가?(47쪽)를 이해하는 과정을 그리고 있다. 죽음의 불가역성을 깨닫는 것은 미래를 예상한다는 것(69쪽) 동료가 죽었다는 사실을 확인하고 나면, 자신들의 관계가 현재에서 과거로 영원히 옮겨갔다는 사실을 아는 것처럼 보인다. 모든 감정은 지식과 섞여 있다.(74쪽) 곤경에 빠진 동물을 적극적으로 찾아가는 행동은 이기적인 시나리오와 들어맞지 않다(153쪽)고 주장한다. soon position(272쪽)과 마키아밸리에 대한 생각에서 위선적인 인간들을 비난한다. 문명구원자 가설은 원주민을 만날 때마다 폭력을 행사한 쪽은 탐험가라고 일축한다.(301쪽) 호모 에코노미쿠스의 죽음을 극적으로 선언(326쪽)하면서 마무리한다. 2023.03.14.화
내가 생각하고 싶어한 바와 달리 삶은 논리가 이끌어가지 않는다. 그보다 삶은 습관적인 행동이라는 관성의 지배를 받는다.(76쪽) 산업화한 문명이 보편적이라는 전제는 사기라는 것, 그리고 소비자로서 생존 양식은 상당수 인구가 채택할 경우 삽시간에 지속 불가능해지고 문자 그대로 지구 행성을 마구 먹어치우는 상태에 이를 것임을 증명해준다.(151쪽) 현재의 기후변화 사건은 오랜 기간에 걸친 인간 행동을 모조리 반영한다는 점에서 역사의 종착역이기도 하다.(155쪽) 사익 추구를 경제의 동력으로 삼는 사회(192쪽)가 과연 정상적인 사회이며, 제한 없는 성장(201쪽)을 숭배하는 것이 과연 합리적이며 달성가능하다고 보는가? 우리는 아무 의심없이 자본주의 논리에 완전히 세뇌되었다. 2023.03.02.목
경전과 다른 방식으로 전승되고(교외별전) 말과 문자에 의존하지 않고(불립문자) 직접 인간의 마음을 인도하고(직지인심) 고유한 본성을 바라보고 부처가 됩니다.(견성성불) 전설적 창시자 보리달마의 시(8쪽) 친숙한 사람과 낯선 사람을 구분하지 않고 공감하는 것, 모든 사람을 차별 없이 구하려고 애쓰는 것, 속세적으로도 탈속적으로도 결코 자기 이익을 생각하지 않는 것, 다른 사람들이 모르고 감사를 표시하지 않아도 그대들의 마음에 따라 그저 다른 사람에게 좋은 일을 하는 것, 그들이 잘되기를 마음속으로 바라는 것을 결코 그들에게 알리지 않는 것 친절에 관한 도겐의 설명(172쪽)은 따르기는 힘들지만 반드시 염두에 둬야할 교훈을 보여준다. 그리고 뭔지 모를 마음의 평화를 불러온다. 2023.02.21.화
지금까지 알았다고 생각했던 상식이 사실이 아니었다니... 자본주의는 전쟁과 정복과 관계없으며 봉건적 과거와 결별한 진보에서 비롯되었다는 그들만의 신화는 허구였다.식민주의, 제노사이드, 폭력의 결과로 북남미를 멸망시키지 않았다면 서구의 자본주의는 발생하지 않았다. 자본주의는 유럽의 산물이 아니라 북남미의 피와 땅으로 이룬 외래의 것이다.(166~7쪽) 북남미의 인구를 절멸시킨 여파로 방대한 경작지가 숲으로 바뀌는 바람에 16세기말과 17세기 초에 이르는 소빙기에 얼마간 기여했을지 모른다는 그의 추측은 끔찍하기만 하다.(76쪽) 2023.01.28.토
90년대에 씌여진 책이지만 한발자욱도 진전되 못한 현실이라서 시의성을 느끼지 못하다니... 이성애제도는 여성에 대한 남성의 지배와 통제를 유지하는 핵심축이다.(84쪽) 결혼한 여성과의 성교를 그 여성의 남편에 대한 범행으로 규정하는 성적으로 비대칭적인 간통법(173쪽) 2023.01,18.수
동물의 행동은 사람이 해야 하는 행동을 뒷받침하는 근거가 될 수 없다.(146쪽) 한스 쿠머의 말인데 인간이 나쁜 행동을 하고서는 동물 핑계를 대지 말라고 충고한다. 진화론은 인간의 사악한 모습을 변명하는 학문이 아니다. 최고의 자질을 갖춘 수컷과 짝짓기를 함으로써 암컷은 진화를 조종한다.(238쪽) 위계와 권력의 구분(314쪽)은 수컷의 위계는 잘 드러나지만 암컷의 실질적인 권력 분점은 숨겨져 있다고 분석한다. 겉으로 보기에는 수컷의 위계가 높지만 그것이 권력의 크기를 말하는 것은 아니다. 그리고 수컷은 암컷의 기존 파트너를 존중하는 모습을 보여 기존의 해석인 새암컷을 좋아한다는 논리를 부순다. 하지만 왜 암컷은 검증된 수컷에 집착하는지 진화를 위한 희생치고는 웃프다. 2023.02.10.금
아리스토텔레스 자유로운 인간이 따르는 삶의 양식 비오스 테오레티코스 진리의사색적 고찰에 헌신하는 삶(139쪽) 고유하게 존재하지 못하는 자가 항상 시간을 잃어버리고, 늘 시간을 가지지 못한다.(86쪽) 루터는 직업으로서의 일을 인간을 향한 신의 부름과 연결시킨다. 캘빈주의에 의해 노동은 구원경제학적 의미를 부여받는다. 오직 일에서의 성공만이 신에게 선택받은 징표로 해석된다. 구원에 대한 근심 때문에 캘빈주의자는 노동자가 된다.(143~4쪽) 노동사회는 일이 절대적인 지위에 이른 사회. 일의 지배는 너무 완벽해져서 노동시간 바깥에는 오직 때우고 죽여야할 시간밖에 없다.(149쪽) 2023.01.04.수
- 좋아요
- 6
- 댓글
- 0
- 작성일
- 2023.1.8
댓글0

아직 댓글이 없어요.
첫 번째 댓글을 남겨보세요.